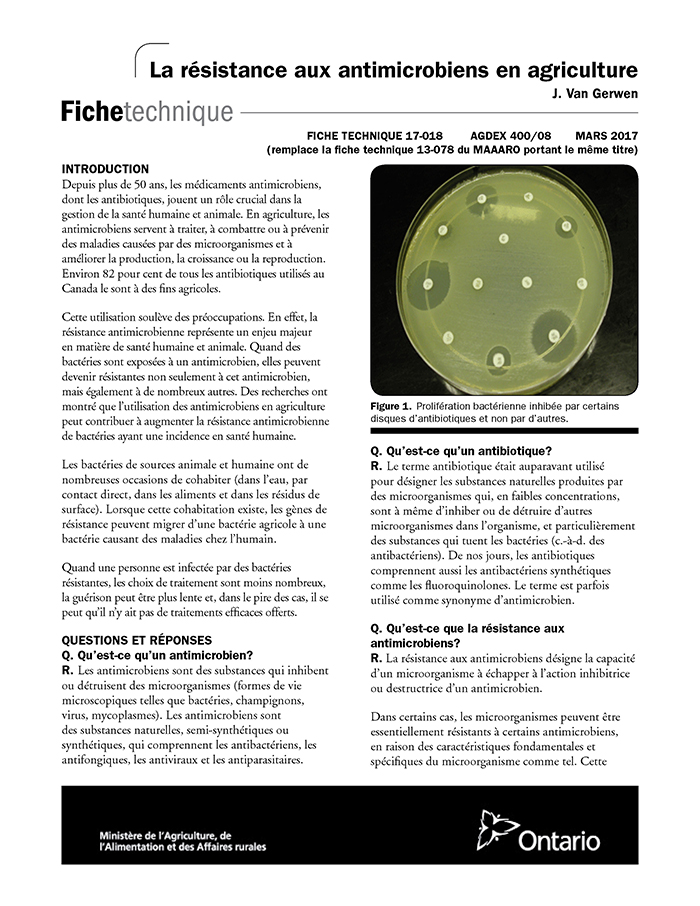

Vous pouvez compléter les synonymes de de nos jours proposés par le dictionnaire de synonymes français reverso en consultant dautres dictionnaires spécialisés dans les synonymes de mots français. Il y a 9 synonymes de actuellement.
Francais De Nos Regions
De nos jours synonyme. Actualités du des présentation du des proposer de nouvelles relations synonymiques ou antonymiques voir les. Dispute et altercation sont des mots synonymes. Ces archives contiennent 200000 titres datant de 1895 à nos jours. Ces synonymes du mot de nos jours vous sont proposés à titre indicatif. Synonymes appropriés pour de nos jours 22 synonymes trouvés 3 définitions différentes mots similaires semblables pour de nos jours comment dit on. Ce mot a été signalé à nos équipes afin quil soit ajouté dans les plus bref délais dans la mesure ou il ny a pas de faute dorthographe.
Dictionnaire des synonymes simple rapide et gratuit. Synonymes nos dans le dictionnaire de synonymes reverso définition voir aussi de nos joursnousnoisenostalgie expressions conjugaison exemples. Tous les synonymes en aperçu. De nos jours de notre temps en ce moment pour le moment antonymes de actuellement. 1 solution pour la definition de nos jours en 6 lettres. à lheure actuelle actuellement aujourdhui de nos jours présentement avant toute consultation merci de lire cet avertissement nouvelle rubrique.
Aimer et être amoureux sont des mots synonymes. De nos jours adj actuellement à lépoque actuelle à lheure actuelle de notre temps par les temps qui courent par le temps qui court de nos jours adv. Aucun résultat pour de nos jours. The russian years from 1895 to the present day 1897 pocketwatch cartier paris1905. Vous utilisez ici les synonymes de de nos jours. The archive holds 200000 titles dating from 1895 to the present day.
Le mot bicyclette eut être considéré comme synonyme de vélo. De nos jours. Définition nombre de lettres solution. En savoir plus. Les années russes de 1895 à nos jours 1897 montre de poche cartier paris1905. Lettres connues et inconnues entrez les lettres connues dans lordre et remplacez les lettres inconnues par un espace.
Cherchez de nos jours et beaucoup dautres mots dans le dictionnaire de synonymes français de reverso. Wikipedia trésor de la langue française lexilogos dictionnaire larousse.





:quality(80):max_bytes(120000)/5dae32edb988f83e3a2cb385/les-synonymes.jpg)